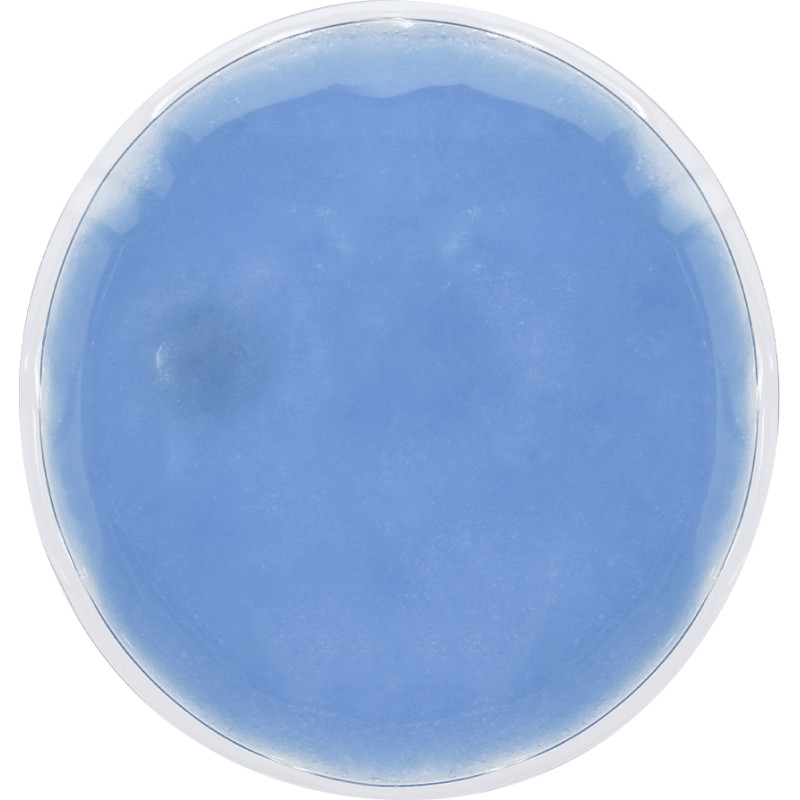

Ostukorv
Teie ostukorv on tühi! Kirjeldus
Reusable
Reusable thermal patch with heat effect in varied colors and long lasting. To activate, bend the metal plate so that the patch hardens and heats up. For reuse, heat water in a container with the patch inside until the inside gel returns to its liquid state and press the metal sheet back together.
Reusable thermal patch with heat effect in varied colors and long lasting. To activate, bend the metal plate so that the patch hardens and heats up. For reuse, heat water in a container with the patch inside until the inside gel returns to its liquid state and press the metal sheet back together.